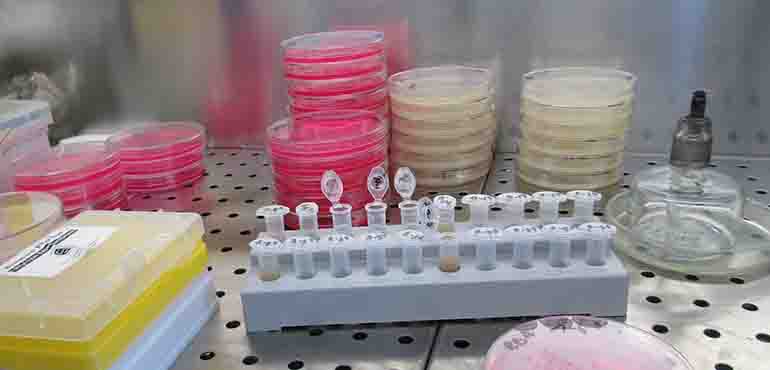

March 1, 2016
NIRvana Sciences Awarded $1.5 million Phase II STTR Grant from NIH RESEARCH TRIANGLE PARK, NC, March 1st, 2016 – National Institute of Allergies and Infectious Diseases (NIAID) at the National Institutes of Health (NIH) awarded NIRvana Sciences a Phase II grant to further develop its bacteriochlorin dyes for use in flow cytometry applications.
September 15, 2015
NIRvana Sciences Establishes Conjugation Lab RESEARCH TRIANGLE PARK, NC, September 15, 2015 – NIRvana Sciences, Inc., the leading developer of synthetic bacteriochlorins and chlorins in the field of fluorescent dyes, announced that in addition to its protein conjugation lab, it has also set-up a dye synthesis lab and hired another chemist, Chih-Yuan Chen, to its team.
May 18, 2015
NIRvana Sciences Awarded NC Dept. of Commerce Phase I Matching Funds RESEARCH TRIANGLE PARK, NC, May 18th, 2015 – NIRvana Sciences, Inc., the leading developer of synthetic bacteriochlorins and chlorins in the field of fluorescent dyes, announced that it has been awarded a $50k Phase I STTR Matching Grant from the One North Carolina Small Business Program supported by NC Department of Commerce’s Office of Science, Technology and Innovation.
10 May 2015
NIRvana Sciences Welcomes Lisa Cooper to Board of Directors RESEARCH TRIANGLE PARK, NC, May, 2015 – NIRvana Sciences, Inc., the leading developer of synthetic bacteriochlorins and chlorins in the field of fluorescent dyes, announced that Lisa Cooper has joined the Board of Directors. Lisa is owner and VP of PMI Ash and brings significant management and IP portfolio
September 01, 2015
NIRvana Sciences Closes Series A
RESEARCH TRIANGLE PARK, NC, September 1st, 2015 – NIRvana Sciences, Inc., the leading developer of synthetic bacteriochlorins and chlorins in the field of fluorescent dyes, announced that it has successfully closed its Series A investment round. The oversubscribed round includes investments from many angel investments groups in North Carolina and South Carolina as well as some private angels.
July 30, 2015
NIRvana Sciences Awarded SRL from NC Biotech Center
RESEARCH TRIANGLE PARK, NC, July 30th, 2015 – NIRvana Sciences, Inc., the leading developer of synthetic bacteriochlorins and chlorins in the field of fluorescent dyes, announced that it has been awarded a $250k Strategic Research Loan from the North Carolina Biotech Center.
June 14, 2014
NIRvana Sciences Welcomes Rich West to Board of Directors
RESEARCH TRIANGLE PARK, NC, June, 2014 – NIRvana Sciences, Inc., the leading developer of synthetic bacteriochlorins and chlorins in the field of fluorescent dyes, announced that Rich West has joined the Board of Directors. Rich is CEO of Baebies and brings significant executive experience from his previous successful exit of Advanced Liquid Logic to Illumina in 2013.
23 May 2014
NIRvana Sciences Welcomes New CSO to Executive Team
RESEARCH TRIANGLE PARK, NC, May 23rd, 2014– NIRvana Sciences, Inc., the leading developer of synthetic bacteriochlorins in the field of fluorescent dyes, today announced that industry scientist, Bruce Pitner, has joined its executive team as Chief Scientific Officer. DOWNLOAD PDF
30 December 2013
NIRvana Sciences wins NC IDEA Grant Award
Since the program’s inception, NC IDEA has awarded 82 grants totaling over $3.1M. NIRvana Sciences is commercializing novel fluorescent dyes developed at NC State University to improve the performance of medical diagnostic and imaging tests used to identify and treat different types of cancers and infectious diseases. DOWNLOAD PDF
NIRvana Sciences is taking multiplexing to the next level
Need more919.354.1053
7020 Kit Creek Road, Suite 230 Research Triangle Park, North Carolina 27709 USA